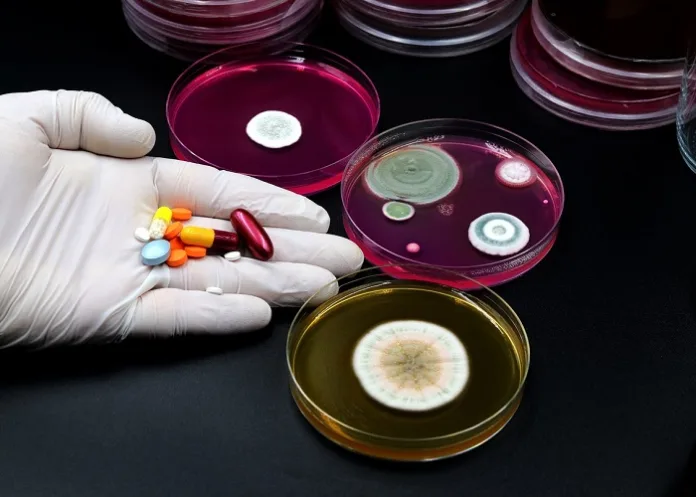

The rapid acceleration of antimicrobial resistance (AMR) is a major concern for the future of global health and modern healthcare, and a particularly urgent threat in the WHO African region, with notable and important differences between countries.
The findings of a paper recently published in The Lancet – part of a collection of studies aiming to describe the regional burden of bacterial AMR – extends the results of the Global Burden of AMR study, providing more granular and country-specific estimates within the WHO African region.
More specifically, based on this estimation of all-age and age-specific deaths and disability-adjusted life-years (DALYs) for 204 countries and territories, the researchers present aggregated estimates for the region in 2019 and its countries.
Disease burden associated with and attributable to AMR was estimated for 12 major infectious syndromes and one residual category, 23 bacterial pathogens, and 88 pathogen-drug combinations.
The first comprehensive global assessment of AMR burden estimated 4.95m deaths associated with bacterial AMR and 1.27m deaths attributable to bacterial AMR in 2019.
The study found that while the threat of AMR is substantial across the globe, its burden is disproportionately high in low-income and middle-income countries (LMICs), including those in sub-Saharan Africa, which often lack access to crucial, more effective antibiotics.
This contributes to the burden, and many of these countries also face unique obstacles when implementing AMR surveillance programmes.
Surveillance obstacles range from lack of national action plans and limited infrastructure and institutional capacity, to reduced investment and human resources, underutilisation of available data, and inadequate dissemination of necessary information to regulatory bodies.
Consequently, the AMR burden in the region has largely remained undefined. Surveillance relies on data from local hospitals, small cohort studies in neonatal and adult wards, laboratory samples collected from patients with suspected infections, and documentation of hospital-acquired infections.
Information gaps
There are major gaps in AMR data in Africa, including measurement of AMR burden in community and hospital settings, animals, and the environment; microbial acquisition of AMR; transmission patterns; genotypic evolution of AMR mechanisms; clonal spread; and asymptomatic carriage.
Furthermore, inadequate AMR preparedness, evidenced by few implemented action plans, suggests the issue has been a low priority for most sub-Saharan Africa countries, and more concerted efforts are urgently needed.
The manuscript was produced as part of the Global Burden of Diseases, Injuries, and Risk Factors Study (GBD) Collaborator Network and in accordance with the GBD Protocol.
Study details
The burden of bacterial antimicrobial resistance in the WHO African region in 2019: a cross-country systematic analysis
Antimicrobial Resistance Collaborators
Published in The Lancet on 19 December 2023
Summary
Background
A critical and persistent challenge to global health and modern healthcare is the threat of antimicrobial resistance (AMR). Previous studies have reported a disproportionate burden of AMR in low-income and middle-income countries, but there remains an urgent need for more in-depth analyses across Africa. This study presents one of the most comprehensive sets of regional and country-level estimates of bacterial AMR burden in the WHO African region to date.
Methods
We estimated deaths and disability-adjusted life-years (DALYs) attributable to and associated with AMR for 23 bacterial pathogens and 88 pathogen–drug combinations for countries in the WHO African region in 2019. Our methodological approach consisted of five broad components: the number of deaths in which infection had a role, the proportion of infectious deaths attributable to a given infectious syndrome, the proportion of infectious syndrome deaths attributable to a given pathogen, the percentage of a given pathogen resistant to an antimicrobial drug of interest, and the excess risk of mortality (or duration of an infection) associated with this resistance. These components were then used to estimate the disease burden by using two counterfactual scenarios: deaths attributable to AMR (considering an alternative scenario where infections with resistant pathogens are replaced with susceptible ones) and deaths associated with AMR (considering an alternative scenario where drug-resistant infections would not occur at all). We obtained data from research hospitals, surveillance networks, and infection databases maintained by private laboratories and medical technology companies. We generated 95% uncertainty intervals (UIs) for final estimates as the 25th and 975th ordered values across 1000 posterior draws, and models were cross-validated for out-of-sample predictive validity.
Findings
In the WHO African region in 2019, there were an estimated 1·05 million deaths (95% UI 829 000–1 316 000) associated with bacterial AMR and 250 000 deaths (192 000–325 000) attributable to bacterial AMR. The largest fatal AMR burden was attributed to lower respiratory and thorax infections (119 000 deaths [92 000–151 000], or 48% of all estimated bacterial pathogen AMR deaths), bloodstream infections (56 000 deaths [37 000–82 000], or 22%), intra-abdominal infections (26 000 deaths [17 000–39 000], or 10%), and tuberculosis (18 000 deaths [3850–39 000], or 7%). Seven leading pathogens were collectively responsible for 821 000 deaths (636 000–1 051 000) associated with resistance in this region, with four pathogens exceeding 100 000 deaths each: Streptococcus pneumoniae, Klebsiella pneumoniae, Escherichia coli, and Staphylococcus aureus. Third-generation cephalosporin-resistant K pneumoniae and meticillin-resistant S aureus were shown to be the leading pathogen–drug combinations in 25 and 16 countries, respectively (53% and 34% of the whole region, comprising 47 countries) for deaths attributable to AMR.
Interpretation
This study reveals a high level of AMR burden for several bacterial pathogens and pathogen–drug combinations in the WHO African region. The high mortality rates associated with these pathogens demonstrate an urgent need to address the burden of AMR in Africa. These estimates also show that quality and access to health care and safe water and sanitation are correlated with AMR mortality, with a higher fatal burden found in lower resource settings. Our cross-country analyses within this region can help local governments to leverage domestic and global funding to create stewardship policies that target the leading pathogen–drug combinations.
The Lancet Global Burden of Disease (Open access)
See more from MedicalBrief archives:
Step forward as first study maps out Africa’s superbug threat
Africa bears the brunt of antimicrobial-resistant bacterial infections
SA’s great misalignment between development and health – Global Burden of Disease study